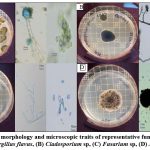

Introduction
Coffea spp., known as coffee, is recognized globally in the world of agricultural industry and commerce, as its unique flavor stands out on the palate of its consumers.1 Coffee has a global market value of $102 billion, resulting in 125 million direct jobs worldwide.2 During 2020-2021, approximately 166.63 million kilograms of coffee bags were consumed globally.3 In Puerto Rico, the coffee industry comprises 34,000 sown acres, resulting in approximately 10,000 direct jobs for agricultural workers during the harvest, and contributing 36 million dollars to the gross agricultural income in Puerto Rico.4 From 2020 through 2021, 329,962 quintals were imported, and 11.43 coffee per pound were consumed on the island, making it the most consumed beverage worldwide.5 However, a diversity of coffee crop diseases can affect the quality and yield of the products.
The relevance of coffee cultivation is intrinsic, however, up to 3,380 species of insects, mites, fungi and bacteria associated with the Coffea genus have been reported.6 In the particular case of Puerto Rico, several diseases were affecting coffee crops, such as coffee leaf rust (Hemileia vastatrix), coffee leaf miner (Leucoptera coffeella), coffee berry borer (Hypothenemus hampei), and anthracnose (Colletotrichum gloeosporioides).7-10
Depending on the causal agent that is causing any affectation in the coffee crop, the treatment strategy is different, however, the approach must be comprehensive, considering different types of control such as ethological, mechanical, cultural, chemical and biological. In the case of diseases caused by phytopathogenic fungi in coffee, the strategies have been based on the use of copper fungicides, but it must be considered that excessive use can cause different inconveniences such as phytotoxicity, copper accumulation in the soil, and outbreaks of pests such as Leucoptera coffeella and Olygonychus ilisis.6,11
Due to this problem, the use of biological control has been sought to be implemented, such as the use of Trichoderma harzianum for the management of Mycena citricolor,12 or the use of Beauveria bassiana commonly known and used by agronomists in various coffee farms in Puerto Rico for its endophytic capacities.13,14 This endophytic fungus has antibacterial, insecticidal, and antifungal activities by producing secondary metabolites and the enzyme chitinase . The protection that B. bassiana brings to coffee plants against Colletotrichum is described as a combined action of both physical exclusions by the colonization of plant tissue and the secondary metabolites produced by B. bassiana. It was confirmed by experiments that B. bassiana could protect coffee beans from rooting when exposed to C. theobromicola and C. tropicale, both responsible for anthracnose.15,16
In this case, it is then necessary to look for additional strategies that can be added for the management of fungi that significantly affect coffee cultivation, such as plants that have been able to confer a mode of self-protection through the synthesis of secondary metabolites that present an activity related to the defense against pathogens with antimicrobial capacity such as phenols, alkaloids, terpenes, lectins and flavonoids, polypeptides, which may have different mechanisms of action to achieve their objective. The methodologies to obtain and evaluate the activity of these metabolites can be variable depending on their nature and may include maceration, fermentation, infusion, decoction and essences.17 One of the most used compounds are the essential oils (EOs), which are secondary plant metabolites extracted from various parts of the plant. They are an excellent substitute for these chemicals because they have natural insecticides and fungicidal activities that help protect crops from various diseases.18 Some essential oils capable of reducing the germination of urediniospores from H. vastatrix (CLR, coffee leaf rust) are citronella, lemongrass, clove, cinnamon, eucalyptus, tea tree, thyme, and neem.19,20 It has been demonstrated that antifungal activities on essential oils, such as Origanum vulgare, can damage the membrane and disrupt its molecular activity causing abnormal metabolism in fungi.21 Origanum vulgare, known as oregano, is frequently used as a medicinal herb due to its value as a plant-based medication in contemporary phytotherapy. It has been proven that essential oregano oil has antimicrobial activities against phytopathogenic fungi on plants due to the presence of terpenes such as carvacrol and thymol.22 Intriguingly, Plectranthus amboinicus is a common plant in Puerto Rico and is even used in Puerto Rican cuisine.23 In addition, Plectranthus amboinicus has antibacterial and fungicidal.24-26 Moreover, Plectranthus amboinicus is used to kill the larvae of mosquitoes, making it an excellent candidate to use as a natural pesticide.27
In recent years, research into the search for new molecules has focused on compounds of plant origin, which in the past were discarded due to their complexity. Today, with the technological tools available for their structural analysis, they have regained relevance, even surpassing others of synthetic origin. This has led to a new impetus and a growing global demand for plants with applications in medicine, agriculture, or the food industry, which in turn has increased interest in plant bioprospecting in search of new beneficial activities such as drugs, pesticides, additives, and others.
In this regard, species of the Lamiaceae family, with commercially important genera such as Plectranthus, Salvia, Ocimum, and Mentha, possess a rich diversity of benefits. Specifically regarding Plectranthus, research has focused on its therapeutic, nutritional, and horticultural properties, due to its aroma and ability to produce essential oils.
Therefore, the aim of this work was to isolate and purify phytopathogenic fungi from coffee plants and evaluate the fungicidal activity of Plectranthus amboinicus extract to establish its potential use in this crop and compare its effectiveness with Origanum vulgare essential oil which has widely documented fungicidal properties.
Materials and Methods
Study location
The coffee crop farm is located at 18° 8′ 41″ N, 66° 38′ 59″ W, with an elevation of 2,205 ft. above sea level in the southern mid of Puerto Rico. During the day, the average temperature is 88° F, but at night it drops to 67°F. The average number of rainy days from May to November is forty-five, with approximately 4673.6 millimeters of water spilled. Furthermore, the area has approximately humidity of 82.54%.
Selection of study plants
For this research, eighteen Coffea arabica var. Limani plants were tagged with numbers to avoid bias in the study. All photos of the location of plants were taken, followed by measuring lesions on secondary branches. The collected data was divided into three control groups: coffee plants exposed to direct sunlight, coffee plants exposed to indirect sunlight, and coffee plants exposed to both direct and indirect sunlight. The number of secondary branches with lesions was divided by the total number of secondary branches in the plant to calculate the lesions percentage. The result was then multiplied by 100. Two seeds from each plant presenting lesions on secondary branches were taken using sterile tweezers, then both seeds were transferred to a sterile tube. Two seeds were taken randomly if the plant did not present any lesions.
Isolation of fungi
We prepared and sterilized Potato Dextrose Agar (and retained it in the autoclave to maintain liquid). Then in the laminar flow hood, we cleaned the samples with NaClO 10% for 10 minutes to eliminate any outside contamination. After 10 minutes, we cleaned the samples two times with sterilized water to remove any excess NaClO left behind. With a scalpel in a sterile tube, seeds were cut using a sterile scalpel to expose the interior of the seeds. Then one mL of sterile water was added to the tube, and 100µl were transferred to the center of the sterile petri dish. Then the liquid PDA was poured into the Petri dish, moving circularly to mix the sample with the medium for the fungi to grow evenly on the Petri dish. Once the PDA with the sample solidified, Petri dishes were transported to an incubator at 25°C for a week. We repeated this process for all samples. Later, under aseptic techniques samples were counted to see the distribution of the fungi. Then six fungi were identified and isolated by scraping a tiny piece of the colony and transferring them from the old Petri dish into a new Petri dish with fresh PDA. Samples were transferred to an incubator at 25°C for a week. Finally, the Petri plates with purified fungi were transferred to a sterilized work area. After that, a drop of blue lactophenol transferred to a clean microscope slide. The fungal colony was carefully touched and transferred into the slide with a sterilized inoculator, followed by a coverslip. Once the slide was prepared and transferred to the microscope, further histological analysis was made. We repeated this process for all samples.28
Obtaining the extract of Plectranthus amboinicus
To develop an extraction, recolected various Plectranthus amboinicus plants in the outside garden area of Centro de Enseñanza e Investigación en Biotecnología y Agrobiotecnología (CEIBA-PUCPR), located in Ponce, Puerto Rico. Leaves were cut from the plants and cleaned with distilled water. Furthermore, distilled water was transferred to an Erlenmeyer and heated at 100°C until boiling. Once cleaned, we weighed the leaves and transferred them to a blender. Leaves and samples were mixed using the (1:1 w/v) factor and left resting for 10 minutes. After ten 10 minutes of incubation, samples were filtered using a Whatman filter paper. Once the extraction had finished, stored it at four degrees Celsius 4°C for 24 h in an amber bottle.
Inhibition assays by disc diffusion method
For the disc diffusion method, we followed the McFarland protocol.29 Fungi suspension was prepared by touching the fungi colony with a loop and transferring a small amount into 1 mL of sterilized water. The turbidity of the sample was compared with the McFarland Standard (MFU) of 0.5 and measured in the spectrophotometer using 600 nm, reaching an absorbance between 0.08-0.10 nm. Once the suspension reached turbidity of 0.5 MFU on the spectrophotometer, 100µl of the fungi suspension were added to the PDA plate, spread with sterile swabs, and left in the room for the absorption for one hour. Then, 20 µL of carvacrol (Sigma Aldrich MO, USA), sterilized water, P. amboinicus extract, and essential oregano oil were added into different sterilized discs. Once the suspension had been absorbed, we transferred the sterilized discs with sterilized tweezers in the middle of the assigned PDA plate. Then, we incubated them at 25℃ for three to seven days. We prepared four replicates; each trial had sixteen PDA plates. The inhibition halo readings were made at three days of growth and seven days of growth.
Determination of the optimal concentration
We calculated the volume of essential oregano oil needed to reach the optimal concentration of carvacrol present in our commercial essential oregano oil. The calculation was as follows:


3mg carvacrol present in essential oregano oil.
Once we knew the concentration of carvacrol on the essential oil that was being added, we modified the initial volume transferred to the Petri dish to obtain the optimal concentration of carvacrol on the essential oregano oil. The calculation was as follows:
![]()
24mg carvacrol present in essential oregano oil.
Once we identified that the volume needed was 0.16mL, we converted it into 160µl. Since the disk could not fully absorb the 160 µL, a gap was created in the solidified PDA using a micropipette tip to transfer the volume into the gap. This step was essential to achieve the carvacrol concentration of 24 mg found in the oregano essential oil. Then, we proceeded to transfer into the gap made with a micropipette tip the following volumes: 40ul of sterilized water (negative control), 40µl of carvacrol (Cat. No. 282197 Sigma Aldrich Co. Missouri) (positive control), and 160µl of essential oregano oil (Natures Answer Co. New York) (experimental control) into each plate. Then, we incubated them at 25°C for seven days. We prepared three replicates; each trial had nine PDA plates. The inhibition halo readings were made at three days of growth and seven days of growth.
Statistical Analysis
Data are presented as the mean values along with their standard errors. An ANOVA test, followed by Tukey’s multiple comparisons post-hoc test, was employed to analyze the percentage of lesions in coffee crops, including the disc diffusion test and optimal concentration. All statistical analyses were conducted using GraphPad version 7.0.
Results
Visual evaluation of the coffee crops showed the presence of evident damages on leaves, branches, and seeds in coffee plants. Visual analysis showed that secondary branches in coffee plants exposed to direct sunlight presented severe symptoms and initiated necrosis. Furthermore, in the secondary branches, the leaves showed small dark spots, and the seeds displayed early stages of root with dark spots and a soft texture. Additionally, the secondary branches in coffee plants exposed to direct and indirect sunlight presented the symptoms. On the other hand, the secondary branches in coffee plants exposed to indirect sunlight showed symptoms at a lower rate or did not affect the plant. Additionally, the secondary branches in coffee plants exposed to direct and indirect light presented the symptoms as the secondary branches exposed to direct light. The coffee plants exposed to direct sunlight presented a high percentage of damages in comparison with coffee plants exposed to indirect sunlight. Additionally, coffee plants exposed to direct and indirect sunlight also presented a high percentage of damage, but not as severe as those exposed to direct sunlight. This tendency shows that symptoms become more severe depending on light exposure which is confirmed by statistical analysis which shows that there is a significant difference (p ≤0.05) in the presence of symptoms in the sampled plants (Figure 1).
![]() |
Figure 1: (A) Distribution of coffee crops located in different light exposure. (B) Percentage of lesions in coffee crops located in different light exposure (n=2-11/group). |
The fungi responsible for sickening the coffee plants were analyzed by purification and wet mount techniques. Color, shape, and scientific literature determined macroscopic traits on the colonies. In contrast, microscopic traits were examined by conidiophores and spores and determined by the Mycology Manual . Figure 2 shows the colony morphology and microscopic traits of Fusarium sp, Aspergillus sp and Cladosporium sp. In figure 2A, among the physical characteristics that stand out in this genre is that the white color predominates in its lower layer. However, on top of the top layer, patterns of green dots can be seen, which characterize the physical properties of Aspergillus spp. Additionally, the conidiophore and spores present were representatives of Aspergillus spp.30 Next, in figure 2B, the colony grew with a white border and a predominating grayish-black color in the center. The physical trait that helped us identify the genre of this fungus was the formation of a cross in the center of the upper layer of the colony. This cross formation is commonly known within the genre of Cladosporium spp. Furthermore, the microscopic traits of the conidiophores and spores were evaluated, and the identity of Cladosporium spp. was confirmed.31 In the physical characteristic of figure 2C, the pattern of the mycelia growth initiates with red at the center, and as it grows, it turns to orange and then light yellow. Mycelial growth is characteristic of Fusarium spp. Subsequently, histological traits indicated that conidiophores and spores belong to Fusarium spp.32 Moreover, in figure 2D morphological traits were similar in figure 2A but differed in color. It can be observed that the pattern of dots is, in fact, white and black, whereas in figure 2A the pattern of dots is white and green. In addition to the morphological traits, microscopic characterization confirmed the identity of another genre species, Aspergillus spp . So, based on the characteristics of the conidiophore and considering its length, texture and color, we think that one of these isolates resembles an Aspergillus niger conidiophore with a thick, smooth, hyaline cell wall, slightly dark brown at the apex (Figure 2D), while the other isolate has a conidiophore with a rough, hyaline wall, with a yellowish-green color characteristic of Aspergillus flavus (Figure 2A).
![]() |
Figure 2: Colony morphology and microscopic traits of representative fungi in coffee seeds sample. (A) Aspergillus flavus, (B) Cladosporium sp, (C) Fusarium sp, (D) Aspergillus niger. |
In the disc diffusion test the results obtained show that there was a significant difference in the capacity to inhibit mycelial growth of the isolated fungi when treated with oregano essential oil treatment compared with the water treatment (p<0.05) except Fusarium spp., however the inhibition of mycelial growth was observed in the fungi in the carvacrol treatment compared with the water treatment (p ≤0.05). In the case of the extract of Plectranthus amboinicus, it did not present inhibition capacity for any of the samples (Figure 3). It is worth mentioning that this may be related to the fact that the effectiveness of plant extracts depends on various factors, including the species and even variety of plant, the extraction methodology, the quality of the plants and the concentration used, to name a few factors.
![]() |
Figure 3: Inhibition measures of the different fungi evaluated in the disc diffusion test. (A) Cladosporium sp, (B) Fusarium sp, (C) Aspergillus flavus, (D) Aspergillus niger. Keys: |
In the test for optimal concentration the fungicidal effect of the positive control carvacrol can be seen on Cladosporium sp, A. niger and A. flavus and Fusarium sp. Moreover, on the third day, comparing the essential oregano oil with water (negative control), there was an inhibition greater than 20mm in all the fungi. However, comparing the seven days of incubation, the growth of all the fungi increased on the plate, decreasing the inhibition halo and indicating that the essential oil is a fungistatic agent (p<0.05). It should be noted that, in Fusarium sp, the fungistatic effect is more notable when comparing the 3rd and 7th day of essential oil (Figure 4).
![]() |
Figure 4: Inhibition measures of the different fungi evaluated in the test for optimal concentration. (A) Cladosporium sp, (B) Fusarium sp, (C) Aspergillus niger, (D) Aspergillus flavus. Keys: |
Discussion
In this research, coffee plants (Coffea arabica var. Limani) were sampled to look for lesions that were presumptive or compatible with fungal infections and to isolate any possible species present. The results obtained show that when coffee plants are exposed to direct sunlight, the percentage of lesions that are presumptive to the presence of fungi increases proportionally, which makes sense since exposure to sunlight can increase the temperature, stimulating mycelial growth and sporulation, making symptoms more severe and easier to observe on coffee plants.33 The isolated fungi belong to the genera Cladosporium, Aspergillus and Fusarium.
Studies show that the appearance of A. flavus and aflatoxin initiate on immature stages of coffee seeds. Furthermore, aflatoxin can remain on the seeds even after roasting because it is thermally stable and not destroyed at 260°C.34 Cladosporium spp. is commonly found in coffee crops; when it encounters green coffee beans, it can contaminate them, decreasing the quality and sensory characteristics of the coffee.35 This infestation occurs because some spores are not completely killed and are carried over to the coffee products.36 Another phytopathogenic fungus in our samples was Fusarium spp. It has been demonstrated that some isolates of Fusarium on coffee seeds produced vascular wilt, chlorosis, and tissue necrosis, causing the total death of the plant. Moreover, infection by Fusarium spp is commonly mistaken for corky root disease. However, it was confirmed in a study that the phytopathogenic action of Fusarium in coffee caused by water stress could be considered as a mimicking effect of root rot involved in corky root disease.37 Subsequently, Aspergillus niger is known for being an opportunistic fungus that is virulent when plant immunity is compromised.38 A. niger produces the mycotoxin ochratoxin A (OTA) commonly found in agricultural products such as coffee.39 OTA is known for being toxic to humans; therefore, the European Union (EU) established that the maximum limit of OTA in roasted coffee is 5 μg/kg, while in soluble coffee is 10 μg/kg.40 This way, OTA can be monitored in a way that does not expose any threat to humans. Since coffee plants are vulnerable due to anthracnose, we analyzed and confirmed that the presence of these fungi on coffee crops might be opportunistic.41-44 Their infestation process becomes easier through sporulation; they benefit from the nutrients of the crops, thereby causing lesions and low-quality products.
The effectiveness of oregano essential oil, a carvacrol standard and P. amboinicus extract was initially evaluated. It was observed that the highest percentage of inhibition (≥ 80 mm) of the mycelial growth of Cladsoporium sp, Fusarium sp, Aspergillus niger and Aspergillus flavus was obtained through carvacrol, followed by oregano essential oil, while the P. amboinicus extract did not show antifungal activity on any of the isolated phytopathogenic fungi. Other results reported) that for a strain of Aspegillus niger at a concentration of 10 % (v/v) of carvacrol by the disk diffusion method they obtained an inhibition zone ≥ 85 mm.45 It should be mentioned that for essential oils to be considered to have antifungal activity, the diameter of the inhibition halos must be greater than 11 mm,46 which was observed in this work. In another study, the fungistatic and fungicidal activity of an aqueous extract of Mexican oregano (Lippia berlandieri) obtained by the hydrodistillation technique for Aspergillus niger was reported, showing total inhibition at 200 ppm,47 while in this study the aqueous extract of P. amboinicus did not show any activity on the isolated fungi, in this case the extract was obtained by decoction. Another study reported that an aqueous extract of Bonellia flammea did not show any activity on the fungus Lasiodiplodia theobromae48 which causes dieback of branches, lesions on stems, generates gum and post-harvest fruit rot.49 Some authors suggest that in some cases the response to the extracts is stimulatory in the sporulation of the fungi as in the case of Alternaria solani with aqueous extracts of Hibiscus rosasinensis, Ricinus comunis, Asclepias glauscecens and Citrus limon.50
Regarding the essential oil used, this was of commercial origin and according to the manufacturer the main component is carvacrol, which is the main volatile component that has been extracted from essential oils of Origanum vulgare. In all the fungi evaluated the antifungal effect of carvacrol was evident, but there were variations depending on the genus of the fungus, with Cladosporium sp and one of the Aspergillus being the most like Aspergillus flavus, which showed greater susceptibility to this compound. In a recent scanning electron microscopy study, it was shown that carvacrol treatment caused morphological deformation in A. flavus mycelia, and the resulting increase in electrolyte leakage indicates damage to the plasma membrane. Confocal scanning laser microscopy confirmed that carvacrol treatment caused a decrease in mitochondrial membrane potential, accumulation of reactive oxygen species, and DNA damage. Transcriptome analysis revealed that the differentially expressed genes were mainly associated with fatty acid degradation, autophagy, peroxisomes, tricarboxylic acid cycle, oxidative phosphorylation, and DNA replication in A. flavus mycelia exposed to carvacrol. Biochemical analyses of hydrogen peroxide and superoxide anion content, and the activities of catalase, superoxide dismutase and glutathione S-transferase showed that carvacrol induced oxidative stress in A. flavus, which was consistent with the results of transcriptome analysis.51
P. amboinicus is cultivated in Malaysia and India, as well as some other Asian countries; however, it is also found in the Americas, even in garden areas. In the Americas, it has different names depending on the region where it is grown; for example, it is known as Cuban oregano, Indian borage, Mexican mint, Mexican thyme, and, as it is commonly known in Puerto Rico, oregano brujo. Regarding its antimicrobial activities, these have been documented against bacteria such as Staphylococcus aureus and Escherichia coli, as well as against fungi such as Aspergillus niger and yeasts such as Candida albicans.
Other studies have shown that extracts from the leaves and essential oils of P. amboinicus have had activity against Aspergillus flavus, Aspergillus niger, Aspergillus ochraceus, Aspergillus oryzae, Candida versatilis, Fusarium sp. GF-1019, Penicillium sp., Saccharomyces cerevisiae, Candida albicans, C. tropicalis, C. krusei, and C. stellatoidea.52
Despite developing an extract from Plectranthus amboinicus, our results showed no inhibition in our samples. We concluded that the extraction method was insufficient to withdraw all the carvacrol and thymol from the leaves of Plectranthus amboinicus since studies have shown they are principal components of P. amboinicus. Various technologies and processes exist for preparing extracts, such as maceration, fermentation, infusion, decoction, and the extraction of essential oils. In this study, maceration of the plant material followed by infusion was chosen. However, the inhibition results against the evaluated fungi were not obtained. This may be because, in the case of infusion, it is recommended to let the mixtures rest until they cool, and in this study, they were only left to rest for 10 minutes, which could reduce the time needed for extracting the active ingredients. It is worth noting that this method was chosen to obtain an extract with antifungal activity that was completely biodegradable, aiming to promote its potential application in organic agriculture. Organic agriculture seeks to minimize the use of synthetic inputs such as pesticides and chemical fertilizers, prioritizing soil fertility and biological activity to create healthy food and protect the environment.
The results of previous studies show that to test the effectiveness of P. amboinicus, it is more appropriate to use it in the form of an essential oil. This could explain why the extract used in this study did not have the desired effectiveness, as it does not meet the characteristics of an essential oil. However, several studies have demonstrated that the extraction of volatile compounds from P. amboinicus is highly variable and influenced by various factors, such as the extraction method used, the origin of the sample (depending on the geographical region from which it is obtained), and the part of the plant used for compound extraction. It is even influenced by the seasons and environmental conditions under which it is collected.
Additionally, other work demonstrated that P. amboinicus could inhibit fungus growth depending on its concentration, making it a viable control for different plant diseases.53
Conclusion
This work lays the foundations of knowledge about the presence of opportunistic fungi in coffee beans and the relevance of a method of treating them with volatile compounds such as carvacrol for post-harvest management.
Acknowledgment
We thank the Pontifical Catholic University of Puerto Rico and the Center for Teaching and Research in Biotechnology and Agrobiotechnology for their support, as well as Corteva Agriscience for funding this project. We are grateful to Central Farm Corporation and Dr. Rigoberto Ramos for granting access to the farm. We also acknowledge the valuable contributions of students Carmen Torres, Maria Landolfi, and Steven A. Díaz to the coffee project.
Funding Sources
The funding source for this study was Corteva Agriscience™ and the Pontifical University of Puerto Rico through its programs supporting scientific and technological research, Grant No. PUCPR-CAS-1-2023.
Conflict of Interest
The authors do not have any conflict of interest
Data Availability statement
The datasets generated and/or analyzed in the current study entitled “Isolation and identification of fungi causing diseases in coffee plantations and their susceptibility to Plectranthus amboinicus” are available from the corresponding author upon reasonable request.
Ethics Statement
This research did not involve human participants, animal subjects, or any material that requires ethical approval.
Informed Consent Statement
The article entitled “Isolation and identification of fungi causing diseases in coffee plantations and their susceptibility to Plectranthus amboinicus and Origanum vulgare” does not contain any human or animal rights.
Author Contributions
Andrea Paola Rivera-Torres: field work, methodology, investigation, supervision, visualization, writing – Original Draft, writing – review and editing.
Xavier Alexis Cruz- González: methodology, analysis of DNA, review.
Juan Acevedo-Alfaro: methodology, planning and supervision.
Taycha Ortiz-Resto: fieldwork, review, analysis of the information
Armando Jared Rodríguez-Rivera: Literature review, original draft, fieldwork, methodology and review.
Nancy Arroyo-González: editing, methodology, planning and supervision.
Gladys Chompré-González: experimental design, methodology, writing, editing, planning, original draft and supervision.
References
- Klingel T, Kremer JI, Gottstein V, Rajcic de Rezende T, Schwarz S, Lachenmeier DW. A review of coffee by-products including leaf, flower, cherry, husk, silver skin, and spent grounds as novel foods within the European Union. Foods. 2020; 9(5):665. 10.3390/foods9050665
- Ridder M. Global Coffee Consumption 2020/21. https://www.statista.com/statistics/292595/global-coffee-consumption/.2022. November 11, 2025.
- Coffee’s Economic Impact. National Coffee Association. https://www.ncausa.org/research-trends/economic-impact. 2023.November 14, 2025
- Meléndez-Ayala I. The Coffee History of Puerto Rico. Whetstone, https://www.whetstonemagazine.com/journal/the-coffee-history-of-puerto-rico.2021. November 16, 2025.
- Nieves R. Senado de Puerto Rico P. del S. 781. Estado Libre asociado de Puerto Rico. ttps://www.tucamarapr.org/dnncamara/Documents/Measures/3577731f-6d02-4bb2-a10f-43b27932dbe3.pdf. 2013. November 27, 2024.
- Barrera JF, Gómez-Ruiz J. Plagas y enfermedades del café: características, manejo y retos. In: Bello- Baltazar E, Soto- Pinto L, Huerta-Palacios G, Gómez-Ruiz J. (eds). Caminar el cafetal: perspectivas socioambientales del café y su gente. México: El Colegio de la Frontera Sur: Juan Pablos Editores; 2019: 115-139.
- Mignucci JS, Hepperly PR, Ballester J, Rodríguez-Santiago C. Anthracnose and berry disease of Coffee in Puerto Rico. The Journal of Agriculture of the University of Puerto Rico. 1985; 69(1):107-117. 10.46429/jaupr.v69i1.7332
- Caicedo J, Álvarez D, Rivera L. Pathogenicity of different strains of coffee rust (Hemileia vastatrix) on Arabic coffee leafs in Puerto Rico. Poster presented at: XIV Mycology Symposium, Puerto Rican Society of Mycology; Aguadillla; April 22, 2013; Puerto Rico.
- Mariño YA, Vega VJ, García JM, Verle Rodrigues JC, García NM, Bayman P. The coffee berry borer (Coleoptera: Curculionidae) in Puerto Rico: distribution, infestation, and population per fruit. Insect Sci. 2017;17(2):1-8. 10.1093/jisesa/iew125
- Johnson MA, Ruiz-Diaz CP, Manoukis NC, Verle Rodrigues JC. Coffee berry borer (Hypothenemus hampei), a global pest of coffee: perspectives from historical and recent invasions, and future priorities. 2020;11(12):882. 10.3390/insects11120882
- de Siqueira Sabino PH, Alves da Silva GO, Bortolotti da Silva A, Andrade Carvalho G. Applications of copper-based fungicides and infestations of Leucoptera coffeella (Guérin-Mèneville & Perrottet) in coffee plants. Coffee Science, Lavras.2019 ;14(1): 123 – 126.
- Barrera JF. Principales plagas y enfermedades del café en México. Claridades Agropecuarias. 2017; 280:16-21.
- Vega FE, Simpkins A, Aime MC, Posada F, Peterson SW, Rehner S.A, Infante F, Castillo A, Arnold AE. Fungal endophyte diversity in coffee plants from Colombia, Hawai’i, Mexico and Puerto Rico. Fungal Ecology. 2010;3 (3):122-138. 1016/j.funeco.2009.07.002
- Gallardo F, Hernández E, Pagán J. Presencia natural del hongo Beauveria bassiana (Bals.) Vuill. en la broca del café Hypothenemus hampei (Ferrari) en Puerto Rico. The Journal of Agriculture of the University of Puerto Rico.2010; 1-2:195-198.
- Serrato-Diaz LM, Mariño YA, Bayman P.Pathogens causing anthracnose and fruit rots of coffee associated with the coffee berry borer and the entomopathogenic fungus Beauveria bassiana in Puerto Rico. Phytopathology. 2020;110(9):1541-1552. 1094/PHYTO-02-20-0057-R
- Ownley BH, Gwinn KD, Vega FE. Endophytic fungal entomopathogens with activity against plant pathogens: Ecology and evolution. BioControl, 2010; 55:113-128. 1007/s10526-009-9241-x
- Manuales Prácticos para la Elaboración de Bioinsumos Elaboración de Extractos Vegetales. Estrategia de Acompañamiento Técnico. Secretaria de Agricultura y Desarrollo Rural 2022., 31p. https://www.gob.mx/cms/uploads/attachment/file/737322/10_Extractos_vegetales.pdf
- de Oliveira TS, Costa AMM, Cabral LMC, Freitas-Silva O, Rosenthal A, Tonon RV. Anthracnose controlled by essential oils: are nanoemulsion-based films and coatings a viable and efficient technology for tropical fruit preservation? Foods. 2023; 12(2): 10.3390/foods12020279
- Borges Pereira R, Lucas G, Perina F, Alves E. Essential oils for rust control on coffee plants. Ciência e Agrotecnologia. 2012; 36:16-24. 10.1590/S1413-70542012000100002.
- Resende M, Pozza E, Reichel T, Botelho D. Strategies for coffee leaf rust management in organic crop systems. 2021;11 (9):1865. 10.3390/agronomy11091865
- Hou H, Zhang X, Zhao T, Zhou L. Effects of Origanum vulgare essential oil and its two main components, carvacrol and thymol, on the plant pathogen Botrytis cinerea. Peer J. 2020;8: e9626. 10.7717/peerj.9626
- Lombrea A, Antal D, Ardelean F, Avram S, Pavel IZ, Vlaia L, Mut AM, Diaconeasa Z, Dehelean CA, Soica C, Danciu C. A recent insight regarding the phytochemistry and bioactivity of Origanum vulgare essential oil. Int J Mol Sci. 2020; 21(24): E9653. 10.3390/ijms21249653
- Arumugam G, Swamy MK, Sinniah UR. Plectranthus amboinicus(Lour.) Spreng: Botanical, Phytochemical, Pharmacological and Nutritional Significance. Molecules. 2016; 21(4):369. 10.3390/molecules21040369
- Murthy PS, Ramalakshmi K, Srinivas P. Fungi-toxic Activity of Indian Borage (Plectranthus amoboinicus) Volatiles. Food Chemistry. 2009; 114 (3):1014-1018. 10.1016/j.foodchem.2008.10.064
- Bhatt P, Negi PS. Antioxidant and antibacterial activities in the leaf extracts of Indian borage (Plectranthus amboinicus). Food and Nutrition Sciences. 2012; 3:146-152. 4236/fns.2012.32022.
- Kumar P, Sangam, Kumar N. Plectranthus amboinicus: A review on its pharmacological and pharmacognostical studies. A J Physiol Biochem Pharmacol.2020; 10(2):55-62. 10.5455/ajpbp.20190928091007
- Vijayakumar S, Vinoj G, Malaikozhundan B, Shanthi S, Vaseeharan B. Plectranthus amboinicus leaf extract mediated synthesis of zinc oxide nanoparticles and its control of methicillin-resistant Staphylococcus aureus biofilm and blood sucking mosquito larvae. Acta A Mol Biomol Spectrosc. 2015; 137:886-891. 10.1016/j.saa.2014.08.064.
- Barnett HL, Hunter BB. Illustrated genera of Imperfect Fungi. 4th ed. New York: APS Press; 2010.
- Felšöciová S, Vukovic N, Jeżowski P, Kačániová M. Antifungal activity of selected volatile essential oils against Penicillium Open Life Sci. 2020;15(1):511-521. 10.1515/biol-2020-0045
- Khan R, Mohamad Ghazali F, Mahyudin NA, Samsudin NIP. Morphological characterization and determination of aflatoxigenic and non-aflatoxigenic Aspergillus flavusisolated from sweet corn kernels and soil in Malaysia. Agriculture. 2020;10(10):1-13. 10.3390/agriculture10100450
- Bensch K, Groenewald JZ, Meijer M, Dijksterhuis J, Jurjević Ž, Andersen B, Houbraken J, Crous PW, Samson RA. Cladosporium species in indoor environments. Studies in Mycology. 2018; 89:177-301. 1016/j.simyco.2018.03.002
- Carreras-Villaseñor N, Rodríguez-Haas JB, Martínez-Rodríguez LA, Pérez-Lira AJ, Ibarra-Laclette E, Villafán E, Castillo-Díaz AP, Ibarra-Juárez LA, Carrillo-Hernández ED, Sánchez-Rangel D. Characterization of two Fusarium solani species complex isolates from the ambrosia beetle Xylosandrus morigerus. J Fungi. 2022;8(3):231. 10.3390/jof8030231
- de Menezes HD, Massola NS, Flint SD, Silva GJ, Bachmann L, Rangel DEN, Braga GUL. Growth under visible light increases conidia and mucilage production and tolerance to UV-B radiation in the plant pathogenic fungus Colletotrichum acutatum. Photochemistry and Photobiology. 2015; 91(2):397-402. 10.1111/php.12410
- Huyong L, Jee-Hoon R, Hoikyung K. Antimicrobial activity of gaseous chlorine dioxide against Aspergillus flavus on green coffee beans. Food Microbiol. 2020; 86: 103308. 10.1016/j.fm.2019.103308
- Kusumaningrum HD, Rasyidah MM. Prevalence of spoilage mold in coffee beans before and after brewing. Food Research. 2019; 3(6):720-726.
- Maman M, Sangchote S, Piasai O, Leesutthiphonchai W, Sukorini H, Khewkhom N. Storage fungi and ochratoxin A associated with arabica coffee bean in postharvest processes in Northern Thailand. Food Control. 2021; 130:108351. 10.1016/j.foodcont.2021.108351
- Gamboa-Becerra R, López-Lima D, Villain L, Breitler JC, Carrión G, Desgarennes D. Molecular and environmental triggering factors of pathogenicity of Fusarium oxysporum and solani isolates involved in the coffee corky-root disease. J Fungi. 2021; 7:253. 10.3390/jof7040253
- Tan LF, Yap VL, Rajagopal M, Wiart C, Selvaraja M, Leong MY, Tan PL. Plant as an alternative source of antifungals against Aspergillus infections: A Review. Plants. 2022; 11(22): 3009. 10.3390/plants11223009
- Al Attiya W, Hassan Z U, Al-Thani R, Jaoua S. Prevalence of toxigenic fungi and mycotoxins in Arabic coffee (Coffea arabica): Protective role of traditional coffee roasting, brewing and bacterial volatiles. PLOS ONE, 2021; 16(10), e0259302. 1371/journal.pone.0259302
- de Almeida ÂB, Corrêa IP, Furuie JL, de Farias Pires T, do Rocio Dalzoto P, Pimentel IC. Inhibition of growth and ochratoxin A production in Aspergillus species by fungi isolated from coffee beans. J. Microbiol.2019; 50(4):1091-1098. 10.1007/s42770-019-00152-9
- Foley K, Fazio G, Jensen A B, Hughes WHO. The distribution of Aspergillus opportunistic parasites in hives and their pathogenicity to honeybees. Vet. Microbiol.2014;169(3-4):203-210. 10.1016/j.vetmic.2013.11.029
- Poulsen JS, Madsen AM, White JK, Nielsen JL. Physiological responses of Aspergillus niger challenged with itraconazole. Antimicrob Agents Chemother. 2021;65(6):1-11. 10.1128/aac.02549-20
- Rosa LH, de Sousa JRP, de Menezes GCA, da Costa Coelho L, Carvalho-Silva M, Convey P, Câmara PEAS. Opportunistic fungi found in fairy rings are present on different moss species in the Antarctic Peninsula. Polar Biology. 2020;43(5):587-596.10.1007/s00300-020-02663-w
- Askun T. Introductory Chapter: Fusarium: Pathogenicity, Infections, Diseases, Mycotoxins and Management. In: Askun T. (ed). Fusarium-Plant Diseases, Pathogen Diversity, Genetic Diversity, Resistance and Molecular Markers. London: IntechOpen; 2018: 1-12. https://doi.org/10.5772/intechopen.76507
- Bouddine L, Louaste B, Achahbar S, Chami N, Chami F, Remmal A. Comparative study of the antifungal activity of some essential oils and their major phenolic components against Aspergillus niger using three different methods. Afr J Biotechnol. 2012;11(76):14083-14087. 10.5897/AJB11.3293.
- Borrego S, Valdés O, Vivar I, Lavin P, Guiamet P, Battistoni P, Gómez de Saravia S, Borges P. Essential oils of plants as biocides against microorganisms isolated from Cuban and Argentine documentary heritage. ISRN Microbiol. 2012; 826786. 10.5402/2012/826786.
- Cáceres Rueda de León I, Colorado -Vargas R, Salas- Muñoz E, Muñoz- Castellanos LN, Hernández- Ochoa L. Actividad antifúngica in vitro de extractos acuosos de especias contra Fusarium oxysporum, Alternaria alternata, Geotrichum candidum, Trichoderma, Penicillum digitatum and Aspergillus niger. Rev Mex Fitopatol. 2013;31 (2):105-112.
- Moo-Koh FA, Cristóbal- Alejo J, Reyes-Ramírez A, Tun-Suárez JM, Sandoval-Luna R, Ramírez-Pool JA. Actividad in vitro del extracto acuoso del Bonellia flammea contra hongos fitopatógenos. Agrociencia. 2014; 48(8):833-845.
- Flores- Hernández H, Flores Gracia J, Varela-Fuentes SE, Pérez-Rodríguez A, Azuara- Domínguez A, Monteon-Ojeda A. Reporte de Lasiodiplodia theobromae (Pat.) Griffon y Maubl. en árboles cítricos de Tamaulipas. Rev Mex Cienc Agric.2021;12(3):499-511.
- Montes-Belmont R, García- Licona R. Efecto de extractos vegetales sobre la germinación de esporas y en los niveles de daño de Alternaria solanien tomate. Rev Mex Fitopatol. 1997; 32 (1):52- 57.
- Duan WY, Zhu XM, Zhang SB, Lv YY, Zhai HC, Ping-An Ma SW, Hu YS. Antifungal effects of carvacrol, the main volatile compound in Origanum vulgare essential oil, against Aspergillus flavus in postharvest wheat. Int J Food Microbiol. 2024; 410:110514. 10.1016/j.ijfoodmicro.2023.110514
- Oliveira RAG, Lima EO, de Souza EL, Vieira WL, Freire KRL, Trajano VN, Lima IO, Silva-Filho RN. Interference ofPlectranthus amboinicus (Lour.) Spreng essential oil on the anti-Candida activity of some clinically used antifungals.Brazilian J. Pharmacog. 2007; 17: 186-190.
- Antonio-Gutiérrez O, Alvízar-Martínez JA, Solano R, Vásquez-López A, Hernández-Valladolid, SL, Lustre-Sánchez H, Flores-Moctezuma HE, de Luna-Santillana E, Lagunez-Rivera L. Microwave-assisted hydrodistillation of essential oil from Plectranthus amboinicus: Evaluation of its antifungal effect and chemical composition. Life, 2023;13(2):528. 10.3390/life13020528